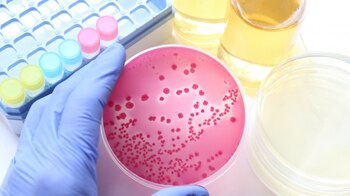

A raíz de importantes brotes de ETA en varios estados de EEUU y episodios en nuestro país, dedicamos unos párrafos a este tema que implica grandes gastos en salud y en vidas humanas, constituyendo un gran problema de salud mundial. Se presentan como casos aislados o brotes infecciosos y han aumentado progresivamente por la expansión del comercio internacional en alimentos.
Se producen por la ingestión de alimentos contaminados por microorganismos o sus toxinas (parásitos, bacterias o virus).
Los más frecuentes que generan brotes alrededor de todo el planeta son producidos por:

- Enterobacterias, principalmente E.coli, Salmonella, Shigella,
- Campylobacter
- Estafilococos,
- Listeria,
- Clostridium,
- Virus productores de hepatitis,
- Rotavirus
- Parásitos : Toxoplasma , Giardia, etc
- Algunos hongos tóxicos.
Los casos de ETA, son provocados por:

- Contaminación del agua: napas contaminadas, falta de potabilización, contaminación secundaria a malas prácticas.
- Técnicas agrícolas deficientes: contaminación de agua de riego.
- Falta de control Microbiológico del agua.
- Falta de higiene en la producción, y elaboración de los alimentos.
- Deficiente transporte de los productos.
- Deficiente temperaturas de conservación y cocción.
- Contaminación cruzada de un alimento por otro por deficiencias en la conservación.
- Portador infectado en la manipulación del alimento.
- Falta de control local e internacional.
- Desarrollo escaso en educación e información a distintos niveles: producción, transporte, elaboración, conservación y venta.
- Domiciliario: falta de información y educación en los hogares con respecto a los puntos de riesgo, desde el lavado de manos hasta óptima. conservación del alimento.
- Frutas, verduras, carnes, lácteos agua, jugos, bebidas, pescados, mariscos, condimentos son la causa de los brotes.
Datos de importancia:

Existen millones de personas sin agua potable en el mundo.
Casos de diarrea por contaminación de alimentos suman 1500 millones por año. La mortalidad por ETA va en aumento (2 millones de personas por año), en donde los menores de 5 años ocupan el 80 % de esos casos, sobre todo en países en desarrollo. En países desarrollados detectan entre 1500 a 1800 brotes por año.
En resumen, es imprescindible elaborar normas modernas para disminuir estas deficiencias y concientizar mediante la educación y la información a toda la población.
La seguridad alimentaria depende de todos.
Dra. Etelvina A. Rubeglio
Directora de Laboratorio de Análisis Biológicos
Últimas Noticias
¿Cuándo iniciarán las clases en colegios estatales por la crisis del gas y qué medidas aplicó el Gobierno en el sector educativo?
Las autoridades buscan reducir el consumo de combustible mientras continúan los trabajos vinculados al ducto de Camisea. La educación presencial en colegios estatales no se modificará

Israel advirtió sobre la amenaza iraní: “No solo atacan a Israel, atacan a la región y al mundo”
El embajador en Argentina, Eyal Sela, detalló en Infobae al Amanecer el impacto de los bombardeos recientes, la situación de los argentinos en la zona y las medidas de seguridad adoptadas en el país. El funcionario remarcó el alcance internacional de la amenaza iraní

En video: jurados de votación en Neiva contaron votos a oscuras por cortes de energía causados por las lluvias
Varias mesas de votación en la Institución Educativa Claretiano GTP resultaron afectadas por las fuertes precipitaciones registradas el domingo 8 de marzo

Ciudadana española ‘se enfrentó’ a una olla a presión colombiana y admitió: “No soy capaz de cerrarla”
La mujer enseñó a sus seguidores que usar este utensilio típico de la cocina colombiana no es tan fácil como parece

Acciones de Booking, Expedia y Travelzoo se disparan ante el retroceso de ChatGPT para ofrecer pagos directos
El cambio de estrategia sugiere que el chatbot seguirá funcionando como una herramienta para investigar y planificar compras


